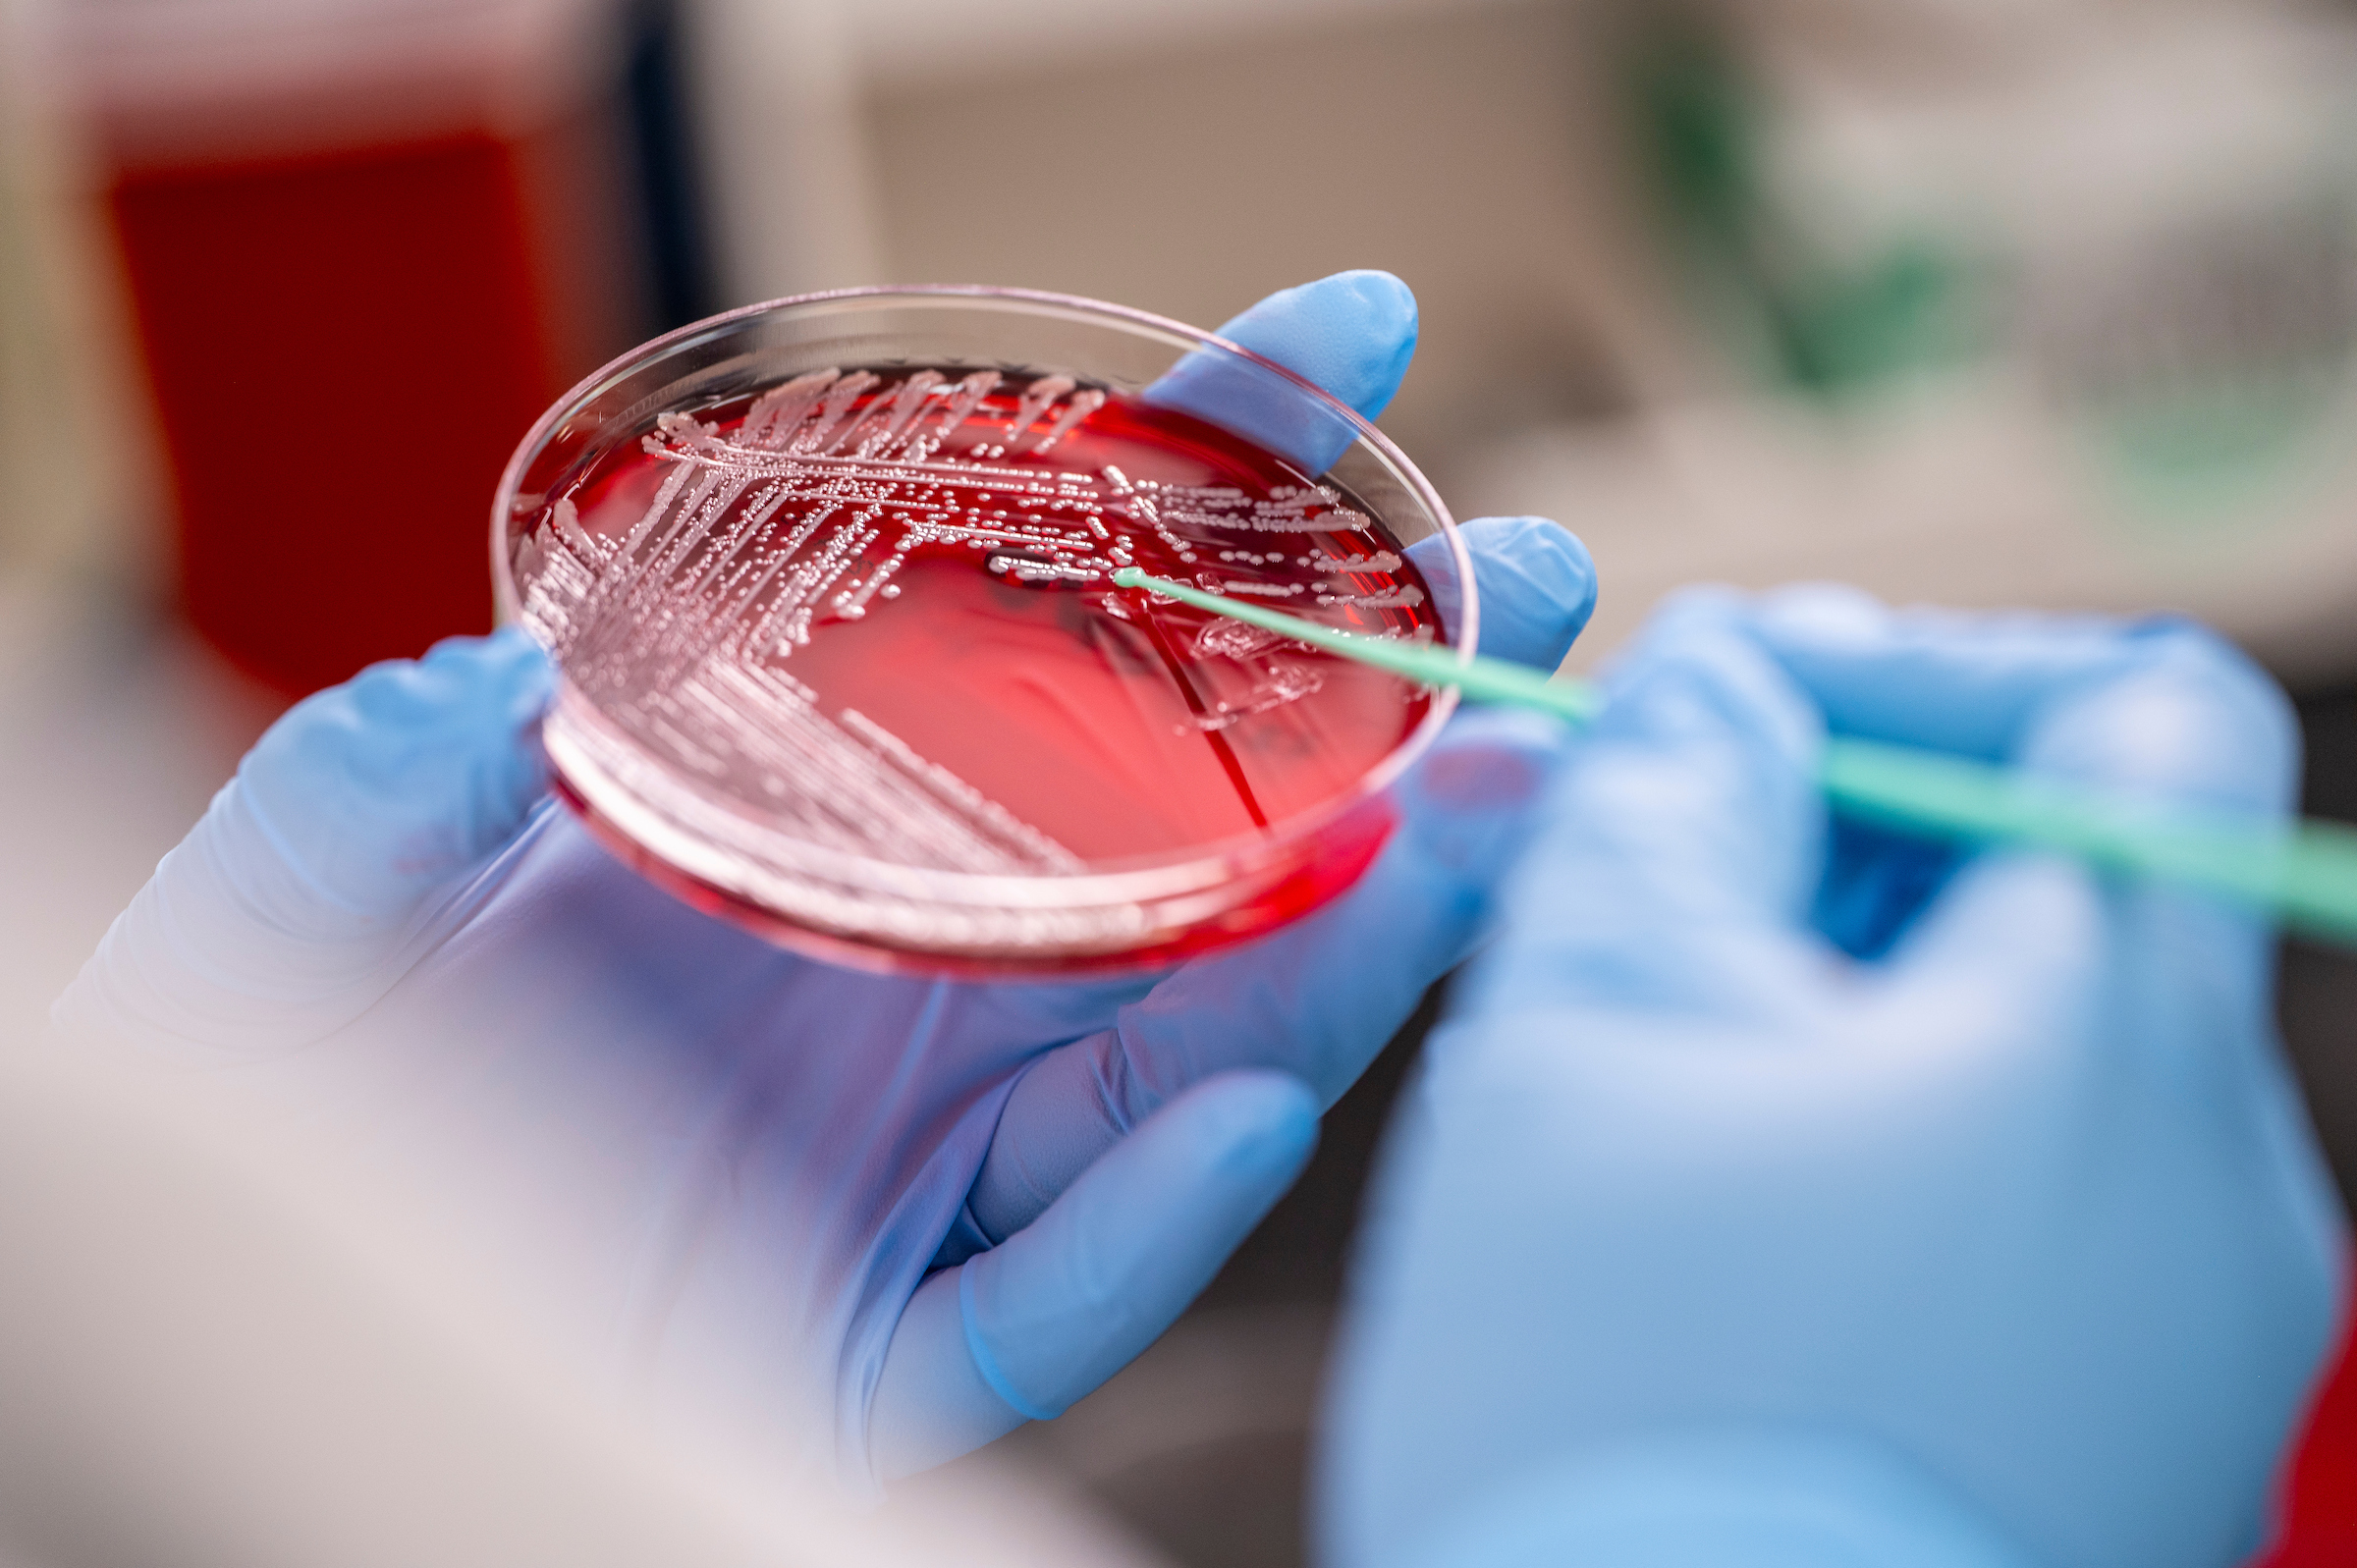

Medical Laboratory Technician (AAS)
Medical lab technicians are in high demand. Prepare for this rewarding career with Saint Francis’ hybrid medical laboratory technician program.
- Available as
- Major
- Degrees/Options
- Associate of Applied Science
- Length
- 2 years
- Locations
- Crown Point
*This program is not currently accepting new students.

Why Become a Medical Laboratory Technician?
Medical lab technicians are vital: their work directly contributes to the diagnosis, treatment, and prevention of disease and medical conditions. You’ll find them on the front lines of patient care, collecting, preparing, and analyzing samples — giving healthcare providers what they need to make important decisions. This field is in high demand and pays well.
Many healthcare employers prefer to hire certified medical lab technicians (MLTs). Saint Francis provides a 2-year, NAACLS-accredited program designed to prepare you for the American Society of Clinical Pathology certification exam. Upon graduation, you will not only be eligible to sit for the exam, but you will have acquired the skills and knowledge to feel confident in the workforce.
100%
Career success rate for our Class of 2024 medical laboratory technician graduates
351,200
Number of jobs for clinical technologists and technicians in 2024
BLS.gov
$61,890
Median national annual salary for clinical technologists and technicians in 2024
BLS.gov
Why Saint Francis for Medical Laboratory Technician?
Our lab programs get results.
It’s clear why 100% of Saint Francis medical laboratory technician graduates find employment in their chosen field. Led by an expert, service-driven faculty, our accredited MLT program gives you a strong foundation in science, hands-on lab experience, and academic and career support along the way. Renowned for its values-based healthcare education, Saint Francis not only prepares you to do your job well but to do it with care and compassion.
Hands-On Learning: Real-World Clinical Experience
Along with your foundational courses, you’ll learn your way around a lab, how to use the equipment and practice techniques. Your path toward MLT certification culminates with hands-on training in a variety of real-world lab settings. Our medical lab tech students complete their rotations at sites such as Alverno Core Laboratories and Franciscan Health locations in:
- Crown Point
- Dyer
- Michigan City

“As soon as I graduated, I was hired into a full-time position from one of my clinical sites. This is typical—my supervisor is also an SF Crown Point graduate.”
LaTasha Patton ’21 Medical Lab Technician, Alverno Laboratories
“I work as a lab assistant and heard about this program as a way to advance my career. I love what it teaches: not just how to work in a lab, but how to be an important part of patient care by doing lab work that helps analyze, diagnose, and treat the patient.”
Stephanie Moreno ’18 Medical Laboratory Technician
“I encourage anyone interested in becoming an MLT to look at USF Crown Point. It’s a great education and there are a lot of jobs available. It’s so rewarding to be part of a team that takes care of patients.”
Rachel Marion ’20 General Laboratory Supervisor, Franciscan Health Munster
“I worked as a lab assistant at Alverno Labs while I was a USF Crown Point student. I was recommended by my Chemistry professor and held the job until I graduated. The next day, Alverno transitioned me into a professional MLT position.”
Melissa Wainscott ’20 Medical Lab Technician, Alverno Laboratories
What You Can Do With a Degree to be a Medical Laboratory Technician?
Graduates of a medical laboratory technician program can find positions in a range of healthcare facilities, from hospitals and outpatient care centers to blood banks and independent labs.
Many MLTs work as generalists, especially at first. As you gain experience, you might discover an area you particularly enjoy and choose to specialize in immunology, hematology, or microbiology, for instance.
Opportunities for Career Advancement
With continued demand for qualified lab workers, there’s considerable room for growth techs with MLT certification. As you gain experience and additional credentials, you could be eligible for specialized lab roles or even supervisory positions.
For many, the associate degree is a stepping stone. Our accredited MLT program is excellent preparation for a related bachelor’s degree.

Accreditation and Outcomes
The MLT Program is accredited by the National Accrediting Agency for Clinical Laboratory Sciences, 5600 N. River Rd., Suite 720, Rosemont, IL 60018-5119.
Upon graduation, students are eligible to sit for certification through American Society for Clinical Pathology (ASCP).
Graduation Rate
- Graduation Rate: 2023: 100%, 2024: 67%, 2025: 67%
- Most Recent 3-Year Average (2023, 2024 and 2025): 75%
Job Placement Rate:
- Job Placement Rate: 2023: 100%, 2024: 100%, 2025: 100%
- Most Recent 3-Year Average (2023, 2024, and 2025): 100%
ASCP Certification Pass Rates
- ASCP Certification Pass Rates: 2023: 100%, 2024: 100%, 2025: 100%
- Most Recent 3-Year Average (2023, 2024, and 2025): 100%


